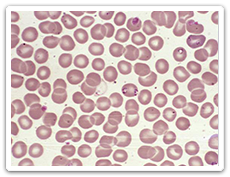
Babesia microti within peripheral blood smear

Babesiosis
Babesiosis is an infection caused by a parasite which is transmitted primarily by the bite of an infected blacklegged tick (Ixodes scapularis) or western blacklegged tick (Ixodes pacificus). Many people infected with Babesiosis have no symptoms. Common symptoms are mild, non-specific and flu-like. The risk of severe illness is greater in older individuals and those with underlying medical conditions. Babesiosis can be successfully treated once diagnosed. Risk of infection can be lowered by preventing tick bites.
Babesiosis is an infection caused by a parasite which is transmitted primarily by the bite of an infected blacklegged tick (Ixodes scapularis) or western blacklegged tick (Ixodes pacificus). Many people infected with Babesiosis have no symptoms. Common symptoms are mild, non-specific and flu-like. The risk of severe illness is greater in older individuals and those with underlying medical conditions. Babesiosis can be successfully treated once diagnosed. Risk of infection can be lowered by preventing tick bites.
Image Content Provider: Dr Mae Melvin US CDC PHIL
Symptoms
Babesiosis symptoms typically appear between 1 to 6 weeks after the bite of an infected tick, or up to 6 months following transfusion of infected blood products. Many people infected with Babesiosis develop no symptoms. For those who do the symptoms are normally non-specific and flu like. Symptoms start with a gradual onset of fatigue and discomfort, followed by one or more of the following: chills, sweats, anorexia, headache, weakness, nausea, non-productive cough and joint pain. Severe illness typically requires hospitalization and commonly occurs in individuals with underlying risk factors such as, old age, compromised immune system and asplenia (lacking a spleen). Mortality rates are low however they are much higher among those who are hospitalized.
Blacklegged ticks can also transmit other infections, such as Anaplasmosis and Lyme disease. Co-infection with either of these may result in symptoms that are more severe and/ prolonged.
Causes
While there are a number of species of Babesia that can cause Babesiosis infection in humans, Babesis microti is the species of concern throughout much of North America. Babesiosis infections normally cycle between the tick vectors and small mammals, mainly the white-footed mouse. Humans can become infected when bitten by an infected blacklegged tick. The highest risk period, May – July coincides with the peak activity of blacklegged tick nymphs.
While still relatively rare, Babesiosis can be transmitted via blood transfusion as the parasites are able to survive for weeks in preserved. Less commonly transmission can also occur from mother to child.
Treatment
Treatment with anti-parasitic drugs is prescribed to those diagnosed with Babesiosis. Symptoms start to resolve within 48 hours following the start of treatment, with most resolving within 1 – 2 weeks. Some symptoms such as fatigue, weakness and anemia may persist for up to 3 months. For with more severe illness the treatment and recovery period may be longer.
Prevention
Restricting exposure to potentially infected blacklegged ticks is the key to preventing Babesiosis.
The risk of encountering potentially infected blacklegged ticks is greatest in blacklegged tick risk areas where surveillance has revealed established tick populations. Outside of these areas the likelihood of encountering blacklegged ticks is significantly lower. Blacklegged ticks are most commonly found in wooded or forested areas, or along the fringes of such areas, as these locations provide them with a suitable humid habitat in which to survive. When active in these areas it is important to adopt preventative measures such as:
- Use trails, whenever possible, and stay to the centre of hiking trails or paths,
- Wear light coloured long pants and long sleeved shirts,
- Tuck in clothing (pants and socks) to create a barrier,
- Use an appropriate tick repellent.
Perform a thorough tick check after spending time outdoors inspect yourself, your children and your pets for blacklegged ticks and remove any found as soon as possible. Do not stop if you find one tick, as there may be more. Bathing soon after coming indoors is a good way to find any ticks. Be sure to check clothing and items such as backpacks which may have come into contact with vegetation as well. Finding and removing ticks in a timely manner can significantly reduce the likelihood of disease transmission.
Manitoba Health Resources
For the Public
Materials can be requested by visiting Health Information Resources and completing the attached form.
- Click here to access the eTick platform, including links to download the free mobile eTick app in both the Google Play or App stores.
- Tick-borne Diseases & Children

Tips for parents, guardians and those working with children to reduce the potential for transmission of tick-borne diseases. - Tick Bite Prevention, Tick Checks and Tick Removal Postcard

Quick reference tool with tips for tick-bite prevention, tick checks and tick removal. - Tick Bite Prevention and Tick Removal – Quick Reference Card

Wallet sized card with tick-bite prevention and tick removal tips. - Landscape Tips to Reduce Ticks

Quick reference tool with tips to make yards less welcoming to ticks and their hosts (ex. mice and deer).
For Health Care Providers
- Tick-borne disease Quick Reference Guide for Health Care Providers NEW
- Tick Collaborative Care Service (TiCCS) – provincial care service for diagnosing and managing cases of possible late Lyme and/ or other emerging tick borne diseases (referral required)
- Tick-borne Infections in Manitoba - Update for Health Care Providers
May 20, 2021 - Tick-borne Disease Clinical Case Report Form

- Babesiosis Communicable Disease Management Protocol

- Archived updates related to Tick-Borne diseases can be found here
Other Resources
- Babesiosis – U.S. Centers for Disease Control and Prevention
- Tick-borne diseases of the United States – Reference Manual for Health Care Providers (U.S. Centers for Disease Control and Prevention)
- Additional resources - Emerging Tick-Borne diseases, surveillance, prevention and travel
Communicable Disease
Control (CDC) Health Links – Info Santé |



